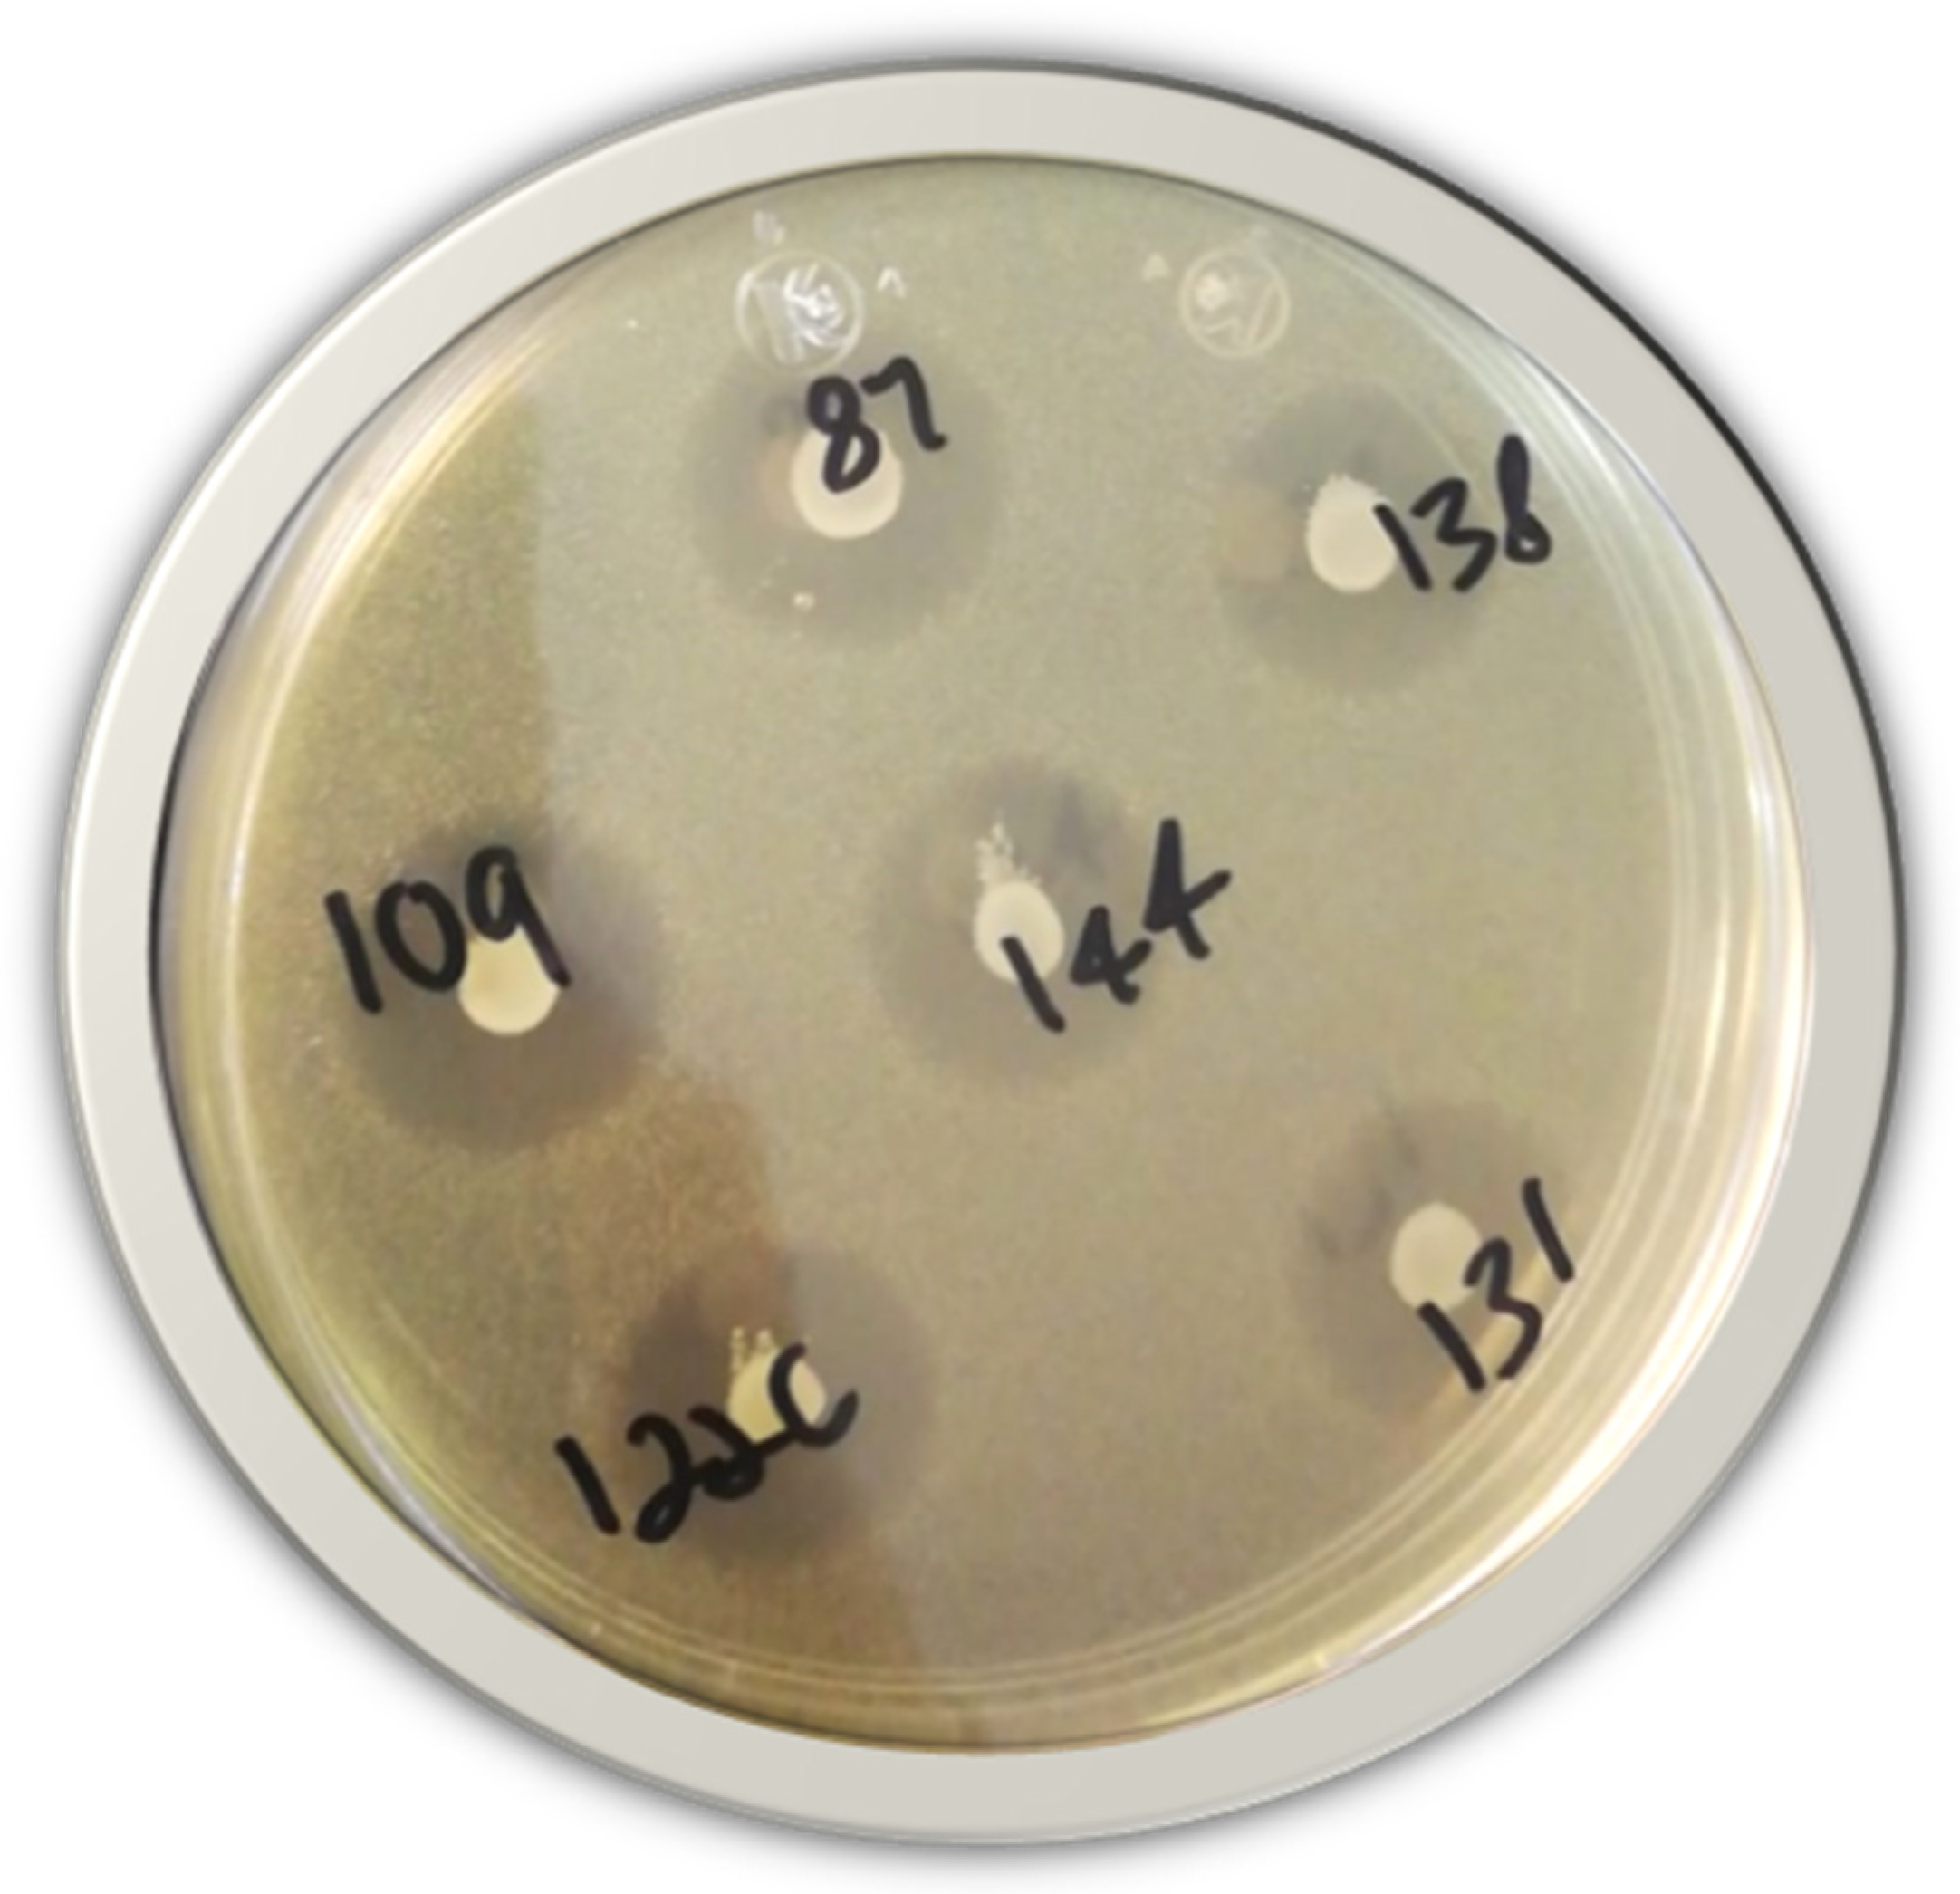
Microbiolres 15 00058 g001

Antagonistic Activity of Bacteriocin-like Inhibitory Substances from Enterococcus lactis Isolated from the Surface of Jalapeno Pepper against Foodborne Pathogens
Abstract
1. Introduction
2. Materials and Methods
2.1. Bacteria Strains: Conditions and Activation
2.2. Screening for LAB from Jalapeno Pepper with Antagonistic Activity against L. monocytogenes
2.3. Preparation and Antagonistic Activity Evaluation of Cell-Free Supernatants (CFSs)
2.4. Identification of the Antagonistic Compound in CFSs and Heat Stability Test
2.5. LAB 16S rRNA Sequence Analysis and Identification
2.6. Minimum Inhibitory Concentration (MIC) and Minimum Bactericidal Concentration (MBC)
2.7. Growth Inhibition Assay against L. monocytogenes
2.8. Statistical Analysis
3. Results
3.1. Jalapeno Pepper’s LAB Antagonistic Activity against L. monocytogenes
3.2. In Vitro Assays of CFSs against Pathogens
3.3. LAB 16S rRNA Sequencing and Identification
4. Discussion
5. Conclusions
Author Contributions
Funding
Institutional Review Board Statement
Informed Consent Statement
Data Availability Statement
Acknowledgments
Conflicts of Interest
References
- González-Pérez, C.J.; Vargas-Arispuro, I.; Aispuro-Hernández, E.; Aguilar-Gil, C.L.; Aguirre-Guzmán, Y.E.; Castillo, A.; Hernández-Mendoza, A.; Ayala-Zavala, J.; Martínez-Téllez, M. Potential Control of Foodborne Pathogenic Bacteria by Pediococcus pentosaceus and Lactobacillus graminis Isolated from Fresh Vegetables. Microbiol. Biotechnol. Lett. 2019, 47, 183–194. [Google Scholar] [CrossRef]
- Todorov, S.D.; Prévost, H.; Lebois, M.; Dousset, X.; LeBlanc, J.G.; Franco, B.D.G.M. Bacteriocinogenic Lactobacillus plantarum ST16Pa isolated from papaya (Carica papaya)—From isolation to application: Characterization of a bacteriocin. Food Res. Int. 2011, 44, 1351–1363. [Google Scholar] [CrossRef]
- Sadiq, S.; Imran, M.; Hassan, M.N.; Iqbal, M.; Zafar, Y.; Hafeez, F.Y. Potential of bacteriocinogenic Lactococcus lactis subsp. lactis inhabiting low pH vegetables to produce nisin variants. LWT Food Sci. Technol. 2014, 59, 204–210. [Google Scholar] [CrossRef]
- Abdelfattah, A.; Freilich, S.; Bartuv, R.; Zhimo, V.Y.; Kumar, A.; Biasi, A.; Salim, S.; Feygenberg, O.; Burchard, E.; Dardick, C.; et al. Global analysis of the apple fruit microbiome: Are all apples the same? Environ. Microbiol. 2021, 23, 6038–6055. [Google Scholar] [CrossRef] [PubMed]
- Gao, Z.; Daliri, E.B.-M.; Wang, J.; Liu, D.; Chen, S.; Ye, X.; Ding, T. Inhibitory effect of lactic acid bacteria on foodborne pathogens: A review. J. Food Prot. 2019, 82, 441–453. [Google Scholar] [CrossRef] [PubMed]
- Verma, D.K.; Thakur, M.; Singh, S.; Tripathy, S.; Gupta, A.K.; Baranwal, D.; Patel, A.R.; Shah, N.; Utama, G.L.; Niamah, A.K.; et al. Bacteriocins as antimicrobial and preservative agents in food: Biosynthesis, separation and application. Food Biosci. 2022, 46, 101594. [Google Scholar] [CrossRef]
- Juturu, V.; Wu, J.C. Microbial production of bacteriocins: Latest research development and applications. Biotechnol. Adv. 2018, 36, 2187–2200. [Google Scholar] [CrossRef] [PubMed]
- Khorshidian, N.; Khanniri, E.; Mohammadi, M.; Mortazavian, A.M.; Yousefi, M. Antibacterial Activity of Pediocin and Pediocin-Producing Bacteria Against Listeria monocytogenes in Meat Products. Front. Microbiol. 2021, 12, 709959. [Google Scholar] [CrossRef] [PubMed]
- Hernandez-Mendoza, E.; Aida Peña-Ramos, E.; Juneja, V.K.; Valenzuela-Melendres, M.; Susana Scheuren-Acevedo, M.; Osoria, M. Optimizing the effects of nisin and NaCl to thermal inactivate Listeria monocytogenes in ground beef with chipotle sauce during sous-vide processing. J. Food Prot. 2023, 86, 100086. [Google Scholar] [CrossRef]
- Zimina, M.; Babich, O.; Prosekov, A.; Sukhikh, S.; Ivanova, S.; Shevchenko, M.; Noskova, S. Overview of Global Trends in Classification, Methods of Preparation and Application of Bacteriocins. Antibiotics 2020, 9, 553. [Google Scholar] [CrossRef]
- Simons, A.; Alhanout, K.; Duval, R.E. Bacteriocins, antimicrobial peptides from bacterial origin: Overview of their biology and their impact against multidrug-resistant bacteria. Microorganisms 2020, 8, 639. [Google Scholar] [CrossRef] [PubMed]
- Hernández-González, J.C.; Martínez-Tapia, A.; Lazcano-Hernández, G.; García-Pérez, B.E.; Castrejón-Jiménez, N.S. Bacteriocins from Lactic Acid Bacteria. A Powerful Alternative as Antimicrobials, Probiotics, and Immunomodulators in Veterinary Medicine. Animals 2021, 11, 979. [Google Scholar] [CrossRef] [PubMed]
- Todorov, S.D.; Dicks, L.M.T. Lactobacillus plantarum isolated from molasses produces bacteriocins active against Gram-negative bacteria. Enzyme Microb. Technol. 2005, 36, 318–326. [Google Scholar] [CrossRef]
- Yi, L.; Qi, T.; Hong, Y.; Deng, L.; Zeng, K. Screening of bacteriocin-producing lactic acid bacteria in Chinese homemade pickle and dry-cured meat, and bacteriocin identification by genome sequencing. LWT Food Sci. Technol. 2020, 125, 109177. [Google Scholar] [CrossRef]
- Saludes, M.; Troncoso, M.; Figueroa, G. Presence of Listeria monocytogenes in Chilean food matrices. Food Control 2015, 50, 331–335. [Google Scholar] [CrossRef]
- Soto Varela, Z.; Pérez Lavalle, L.; Estrada Alvarado, D. Bacterias causantes de enfermedades transmitidas por alimentos: Una mirada en Colombia. Rev. Salud Uninorte 2016, 32, 105–122. [Google Scholar] [CrossRef]
- Contreras-Soto, M.B.; Medrano-Félix, J.A.; Ibarra-Rodríguez, J.R.; Martínez-Urtaza, J.; Chaidez, Q.C.; Castro-del Campo, N. The last 50 years of Salmonella in Mexico: Sources of isolation and factors that influence its prevalence and diversity. Revista Bio Ciencias. 2019, 6, 540. [Google Scholar] [CrossRef]
- CDC Foodborne Germs and Illnesses|CDC 2023. Available online: https://www.cdc.gov/foodsafety/foodborne-germs.html (accessed on 8 November 2022).
- CDC Foodborne Outbreaks|CDC 2023. Available online: https://www.cdc.gov/foodsafety/outbreaks/index.html (accessed on 8 November 2022).
- World Bank. Food-borne Illnesses Cost US$ 110 Billion Per Year in Low- and Middle-Income Countries 2018. Available online: https://www.worldbank.org/en/news/press-release/2018/10/23/food-borne-illnesses-cost-us-110-billion-per-year-in-low-and-middle-income-countries (accessed on 9 November 2022).
- Townsend, A.; Strawn, L.K.; Chapman, B.J.; Dunn, L.L. A systematic review of Listeria species and Listeria monocytogenes prevalence, persistence, and diversity throughout the fresh produce supply chain. Foods 2021, 10, 1427. [Google Scholar] [CrossRef] [PubMed]
- Hilal Cadi, B.; Citak, S. A Comparison of Two Methods Used for Measuring Antagonistic Activity of Lactic Acid Bacteria. Pak. J. Nutr. 2005, 4, 237–241. [Google Scholar] [CrossRef]
- Cruz-Guerrero, A.; Hernández-Sánchez, H.; Rodríguez-Serrano, G.; Gómez-Ruiz, L.; García-Garibay, M.; Figueroa-González, I. Commercial probiotic bacteria and prebiotic carbohydrates: A fundamental study on prebiotics uptake, antimicrobials production and inhibition of pathogens. J. Sci. Food Agr. 2014, 94, 2246–2252. [Google Scholar] [CrossRef]
- Sambrock, J.; Fritsch, E.F.; Maniatis, T. Molecular Cloning, A Laboratory Manual, 2nd ed.; Cold Spring Harbor Laboratory Press: Cold Spring Harbor, NY, USA, 1989; Volumes 1–3, ISBN 0-87969-309-6. [Google Scholar]
- Funke, G.; Funke-Kissling, P. Performance of the New VITEK 2 GP Card for Identification of Medically Relevant Gram-Positive Cocci in a Routine Clinical Laboratory. J. Clin. Microbiol. 2005, 43, 84–88. [Google Scholar] [CrossRef] [PubMed]
- Morales-Figueroa, G.G.; Pereo-Vega, G.D.; Reyna-Murrieta, M.E.; Pérez-Morales, R.; López-Mata, M.A.; Sánchez-Escalante, J.J.; Tapia-Rodriguez, M.R.; Ayala-Zavala, J.F.; Juárez, J.; Quihui-Cota, L. Antibacterial and Antioxidant Properties of Extracts of Yucca Baccata, a Plant of Northwestern Mexico, against Pathogenic Bacteria. Biomed. Res. Int. 2022, 2022, 9158836. [Google Scholar] [CrossRef] [PubMed]
- Li, Y.Q.; Gu, C.T. Proposal of enterococcus Xinjiangensis Ren et al. 2020 as a later heterotypic synonym of enterococcus Lactis Morandi et al. 2012. Int J Syst Evol Microbiol 2021, 71, 004716. [Google Scholar] [CrossRef] [PubMed]
- Belloso Daza, M.V.; Cortimiglia, C.; Bassi, D.; Cocconcelli, P.S. Genome-based studies indicate that the enterococcus faecium clade b strains belong to enterococcus lactis species and lack of the hospital infection associated markers. Int. J. Syst. Evol. Microbiol. 2021, 71, 004948. [Google Scholar] [CrossRef] [PubMed]
- Kim, E.; Kim, D.S.; Yang, S.M.; Kim, H.Y. The accurate identification and quantification of six Enterococcus species using quantitative polymerase chain reaction based novel DNA markers. LWT Food Sci. Technol. 2022, 166, 113769. [Google Scholar] [CrossRef]
- Morandi, S.; Cremonesi, P.; Povolo, M.; Brasca, M. Enterococcus lactis sp. nov., from Italian raw milk cheeses. Int. J. Syst. Evol. Microbiol. 2012, 62(Pt_8), 1992–1996. [Google Scholar] [CrossRef] [PubMed]
- Martín, I.; Rodríguez, A.; Delgado, J.; Córdoba, J.J. Strategies for biocontrol of Listeria monocytogenes using lactic acid bacteria and their metabolites in ready-to-eat meat- and dairy-ripened products. Foods 2022, 11, 542. [Google Scholar] [CrossRef] [PubMed]
- Hanchi, H.; Mottawea, W.; Sebei, K.; Hammami, R. The genus Enterococcus: Between probiotic potential and safety concerns-an update. Front. Microbiol. 2018, 9, 1791. [Google Scholar]
- Ben Braïek, O.; Morandi, S.; Cremonesi, P.; Smaoui, S.; Hani, K.; Ghrairi, T. Biotechnological potential, probiotic and safety properties of newly isolated enterocin-producing Enterococcus lactis strains. LWT Food Sci. Technol. 2018, 92, 361–370. [Google Scholar] [CrossRef]
- Ankaiah, D.; Esakkiraj, P.; Perumal, V.; Ayyanna, R.; Venkatesan, A. Probiotic characterization of Enterococcus faecium por1: Cloning, over expression of Enterocin-A and evaluation of antibacterial, anti-cancer properties. J. Funct. Foods 2017, 38, 280–292. [Google Scholar] [CrossRef]
- Da Costa, R.J.; Voloski, F.L.S.; Mondadori, R.G.; Duval, E.H.; Fiorentini, Â.M. Preservation of Meat Products with Bacteriocins Produced by Lactic Acid Bacteria Isolated from Meat. J. Food Qual. 2019, 2019, 4726510. [Google Scholar] [CrossRef]
- Gutiérrez-Cortés, C.; Suarez, H.; Buitrago, G.; Nero, L.A.; Todorov, S.D. Characterization of bacteriocins produced by strains of Pediococcus pentosaceus isolated from Minas cheese. Ann. Microbiol. 2018, 68, 383–398. [Google Scholar] [CrossRef]
- Kasimin, M.E.; Shamsuddin, S.; Molujin, A.M.; Sabullah, M.K.; Gansau, J.A.; Jawan, R. Enterocin: Promising biopreservative produced by Enterococcus sp. Microorganisms 2022, 10, 684. [Google Scholar] [CrossRef] [PubMed]
- Gupta, A.; Tiwari, S.K.; Netrebov, V.; Chikindas, M.L. Biochemical Properties and Mechanism of Action of Enterocin LD3 Purified from Enterococcus hirae LD3. Probiotics Antimicrob. Proteins 2016, 8, 161–169. [Google Scholar] [CrossRef] [PubMed]
- Du, R.; Ping, W.; Ge, J. Purification, characterization and mechanism of action of enterocin HDX-2, a novel class IIa bacteriocin produced by Enterococcus faecium HDX-2. LWT Food Sci. Technol. 2022, 153, 112451. [Google Scholar] [CrossRef]
- Franz, C.M.A.P.; Schillinger, U.; Holzapfel, W.H. Production and characterization of enterocin 900, a bacteriocin produced by Enterococcus faecium BFE 900 from black olives. Int. J. Food Microbiol. 1996, 29, 255–270. [Google Scholar] [CrossRef] [PubMed]
- Benkerroum, N.; Sandine, W.E. Inhibitory Action of Nisin Against Listeria monocytogenes. J. Dairy. Sci. 1988, 71, 3237–3245. [Google Scholar] [CrossRef] [PubMed]
- Qiao, X.; Du, R.; Wang, Y.; Han, Y.; Zhou, Z. Purification, characterization and mode of action of enterocin, a novel bacteriocin produced by Enterococcus faecium TJUQ1. Int. J. Biol. Macromol. 2020, 144, 151–159. [Google Scholar] [CrossRef] [PubMed]
- Line, J.E.; Svetoch, E.A.; Eruslanov, B.V.; Perelygin, V.V.; Mitsevich, E.V.; Mitsevich, I.P.; Levchuk, V.P.; Svetoch, O.E.; Seal, B.S.; Siragusa, G.R.; et al. Isolation and purification of enterocin E-760 with broad antimicrobial activity against Gram-positive and Gram-negative bacteria. Antimicrob. Agents Chemother. 2008, 52, 1094–1100. [Google Scholar] [CrossRef]
- Wu, Y.; Pang, X.; Wu, Y.; Liu, X.; Zhang, X. Enterocins: Classification, synthesis, antibacterial mechanisms and food applications. Molecules 2022, 27, 2258. [Google Scholar] [CrossRef]
- Pérez-Ramos, A.; Madi-Moussa, D.; Coucheney, F.; Drider, D. Current knowledge of the mode of action and immunity mechanisms of LAB-bacteriocins. Microorganisms 2021, 9, 2107. [Google Scholar] [CrossRef] [PubMed]

| Strains | Designation |
|---|---|
| Listeria monocytogenes | ATCC 7644 |
| Staphylococcus aureus | ATCC 6538 |
| Escherichia coli O157:H7 | K3999 (FDA/CFSAN) |
| Salmonella Typhimurium | ATCC 14028 |
| Enterococcus | Growth Rate (OD/h) | Lag (h) | R2 |
|---|---|---|---|
| 67 | 0.1256 | 12.99 | 0.99 |
| 144 | 0.1616 | 6.26 | 0.99 |
| 172 | 0.2891 | 12.17 | 0.99 |
| 205 | 0.2212 | 6.59 | 0.99 |
| L. monocytogenes | 0.7355 | 5.15 | 0.99 |
| Pathogen | MIC (mg/mL) | MBC (mg/mL) |
|---|---|---|
| L. monocytogenes | 80 | 320 |
| S. aureus | 80 | 320 |
| S. Typhimurium | 150 | 250 |
| E. coli O157:H7 | 250 | 400 |
| Enterococcus | Antibiotic | |||||||||||
|---|---|---|---|---|---|---|---|---|---|---|---|---|
| AMP | GEN | STR | CIP | LEX | ERI | LZD | VAN | DOX | TCY | TIG | NIT | |
| 12 | S | S | S | S | S | I | S | S | I | I | S | I |
| 13 | S | S | S | S | S | I | S | S | S | S | S | I |
| 64 | S | S | S | S | S | I | S | S | S | S | S | S |
| 67 | S | S | S | S | S | I | S | S | S | S | S | I |
| 78 | S | S | S | S | S | I | S | S | S | S | S | I |
| 87 | S | S | S | S | S | I | S | S | S | S | S | I |
| 109 | S | S | S | S | S | I | R | R | R | I | S | I |
| 122 | S | S | S | S | S | I | S | S | S | S | S | I |
| 131 | S | S | S | S | S | I | S | S | S | S | S | I |
| 138 | S | S | S | S | S | I | S | S | S | S | S | I |
| 144 | S | R | S | S | S | I | R | S | R | I | S | I |
| 155 | S | S | S | S | S | I | S | S | S | S | S | I |
| 166 | S | S | S | S | S | I | S | S | S | S | S | I |
| 172 | S | S | S | S | S | I | S | S | S | S | S | I |
| 205 | S | S | S | S | S | I | S | S | S | S | S | I |
| 220 | S | S | S | S | S | I | S | S | S | S | S | I |
Disclaimer/Publisher’s Note: The statements, opinions and data contained in all publications are solely those of the individual author(s) and contributor(s) and not of MDPI and/or the editor(s). MDPI and/or the editor(s) disclaim responsibility for any injury to people or property resulting from any ideas, methods, instructions or products referred to in the content. |
© 2024 by the authors. Licensee MDPI, Basel, Switzerland. This article is an open access article distributed under the terms and conditions of the Creative Commons Attribution (CC BY) license (https://creativecommons.org/licenses/by/4.0/).
Share and Cite
Hernandez-Mendoza, E.; Peña-Ramos, E.A.; Juneja, V.K.; Martínez-Téllez, M.Á.; González-Ríos, H.; Paredes-Aguilar, M.d.l.C.; Valenzuela-Melendres, M.; Aispuro-Hernández, E. Antagonistic Activity of Bacteriocin-like Inhibitory Substances from Enterococcus lactis Isolated from the Surface of Jalapeno Pepper against Foodborne Pathogens. Microbiol. Res. 2024, 15, 889-899. https://doi.org/10.3390/microbiolres15020058
Hernandez-Mendoza E, Peña-Ramos EA, Juneja VK, Martínez-Téllez MÁ, González-Ríos H, Paredes-Aguilar MdlC, Valenzuela-Melendres M, Aispuro-Hernández E. Antagonistic Activity of Bacteriocin-like Inhibitory Substances from Enterococcus lactis Isolated from the Surface of Jalapeno Pepper against Foodborne Pathogens. Microbiology Research. 2024; 15(2):889-899. https://doi.org/10.3390/microbiolres15020058
Chicago/Turabian StyleHernandez-Mendoza, Ezequiel, Etna Aida Peña-Ramos, Vijay K. Juneja, Miguel Ángel Martínez-Téllez, Humberto González-Ríos, María de la Cruz Paredes-Aguilar, Martin Valenzuela-Melendres, and Emmanuel Aispuro-Hernández. 2024. "Antagonistic Activity of Bacteriocin-like Inhibitory Substances from Enterococcus lactis Isolated from the Surface of Jalapeno Pepper against Foodborne Pathogens" Microbiology Research 15, no. 2: 889-899. https://doi.org/10.3390/microbiolres15020058
APA StyleHernandez-Mendoza, E., Peña-Ramos, E. A., Juneja, V. K., Martínez-Téllez, M. Á., González-Ríos, H., Paredes-Aguilar, M. d. l. C., Valenzuela-Melendres, M., & Aispuro-Hernández, E. (2024). Antagonistic Activity of Bacteriocin-like Inhibitory Substances from Enterococcus lactis Isolated from the Surface of Jalapeno Pepper against Foodborne Pathogens. Microbiology Research, 15(2), 889-899. https://doi.org/10.3390/microbiolres15020058








